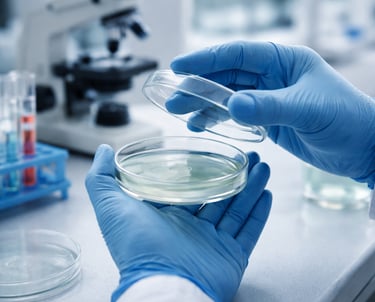

Sobre Mí: Pasión por la Microbiología
¡Hola! Te doy la bienvenida a MicrobioOnline.
Soy Bacterióloga y Laboratorista Clínica colombiana, fundadora de este espacio dedicado a la ciencia.
Mi trayectoria profesional suma más de 5 años de experiencia trabajando activamente en laboratorios clínicos a lo largo del territorio nacional. Durante este tiempo, he vivido de primera mano los retos del diagnóstico diario y la importancia de la precisión en nuestra labor. Además, complementé mi formación con una Especialización en Microbiología Industrial, lo que me permite tener una visión integral de los microorganismos: tanto desde el impacto en la salud humana como en sus aplicaciones industriales.
Este proyecto surge de mi profunda pasión por las ciencias microbiológicas. Me di cuenta de que muchas veces la información científica es difícil de encontrar o complicada de entender.
Mi misión aquí es clara: Ayudar a estudiantes, colegas y apasionados de la ciencia a entender el mundo microscópico de forma fácil, visual y práctica. Quiero ser ese puente que traduce los textos complejos en guías útiles para tu formación académica y tu vida profesional.
Gracias por leerme y ser parte de esta comunidad.
Atentamente,Tu colega y fundadora de MicrobioOnline.

¿Por qué nace MicrobioOnline?
Conocimiento
Difundimos ciencia en microbiología y laboratorio clínico.
Recursos
Contacto
info@microbioonline.com
© 2026 Microbioonline. Todos los derechos